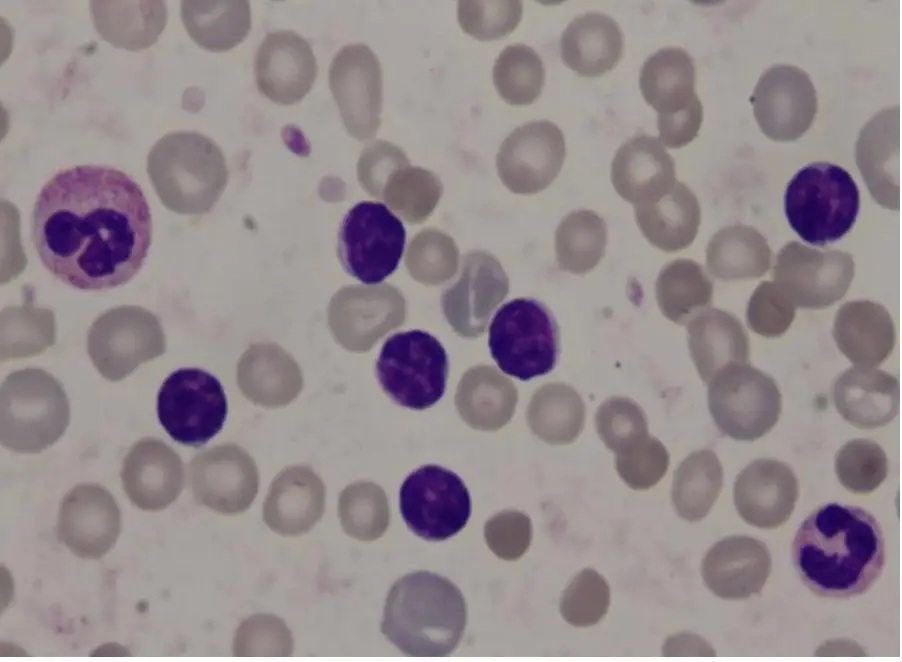
圖片描述

105年:內專
一位63歲男性在健檢時被發現白血球數目增高,其血液抹片如圖所示。這些細胞表現CD5/CD19/CD20/CD23,但CD2/CD3/CD10為陰性。這位病人最可能的診斷為?
AChronic myeloid leukemia
BB cell chronic lymphocytic leukemia
CFollicular lymphoma
DMantle cell lymphoma
EAdult T cell lymphoma/leukemia
詳細解析
本題觀念:
慢性淋巴球性白血病(B cell chronic lymphocytic leukemia, B-CLL)是最常見的成人白血病,以小型成熟 B 淋巴球的單株增殖為特徵。診斷需結合血液抹片形態學與流式細胞儀免疫表現型分析。本題為典型 CLL 免疫表現型組合考題,需熟悉各 B 細胞淋巴增生性疾病的 CD 抗原標記差異。
影像分析:
血液抹片(peripheral blood smear)顯示大量小型成熟淋巴球,其特徵為:
- 核染色質(chromatin):緻密、塊狀凝集(clumped/condensed chromatin),形似「足球」紋路,核仁不明顯
- 細胞質:極少,呈淡藍色狹窄邊緣(narrow rim of basophilic cytoplasm)
- 細胞大小:與正常成熟小淋巴球相近,缺乏原始細胞(blast)外觀
- 背景:可見正常紅血球與少數其他白血球(包括嗜中性球),淋巴球數量相對突出
- 注意:圖中未明顯出現塗抹細胞(smudge cells),但 smudge cells 為 CLL 血液抹片的經典附加特徵,係因 CLL 細胞機械脆弱性增加所致
上述形態學與本題 CD5+/CD19+/CD20+/CD23+ 之免疫表現型高度吻合,符合 B-CLL 診斷。
選項分析
**(A)
...(解析預覽)...

升級 VIP 解鎖圖文解析